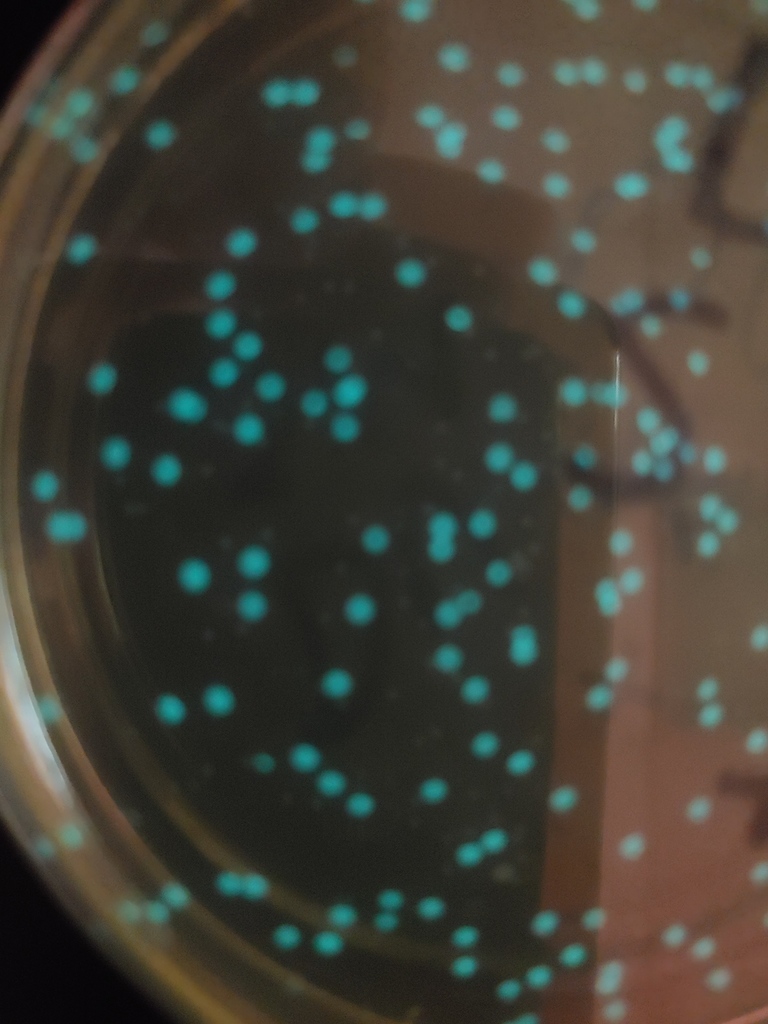
AP Bio students

It’s getting colder by the minute at rehearsals for Frozen Jr. Come “Let It Go” with this spectacular cast on May 1 and 2 at Endeavour Middle School!

Spring is here, and that means it’s time for the Easter Eggs-perience at Stahls Motors & Music Experience!
Join us Saturday, April 4 from 11 AM–4 PM for crafts, an Easter egg hunt, photos with the Easter Bunny, and more family fun. Bring the kids and celebrate the season with us!
Join us Saturday, April 4 from 11 AM–4 PM for crafts, an Easter egg hunt, photos with the Easter Bunny, and more family fun. Bring the kids and celebrate the season with us!

NHCS athletic schedule for the week of 3/22/26.

A busy week at Endeavour! Liam the Leprechaun stopped by, and we’re continuing to celebrate March is Reading Month.




Sophia and Jenivive topped the charts, reciting 105 and 100 digits of pi, respectively. Incredible job, ladies. That definitely deserves a slice of pie!


Interested in coaching girls basketball? We’re looking for dedicated individuals to join our team. Please reach out to Mr. McMahon at jmcmahon@newhaven.misd.net
for more information.
for more information.

🚨🌟 STATE OFFICER. STATEWIDE IMPACT. HISTORY MADE. 🌟🚨
New Haven High School is proud to celebrate an extraordinary achievement by Brayden Celeste, who has been elected as a Michigan DECA State Officer, representing over 10,000 members across the state of Michigan. 👏🔥
After advancing through a highly competitive and rigorous selection process—including a formal interview in Lansing, a full campaign, and election by voting delegates from across the state—Brayden earned his place among Michigan’s top student leaders.
🎤 “Mrs. M believed in me before anyone else did. This means everything, and I’m proud to represent New Haven on the biggest stage.”
As a State Officer, Brayden will:
✨ Lead statewide initiatives
✨ Represent Michigan at conferences across the country
✨ Mentor thousands of student leaders
✨ Serve as the voice of Michigan DECA
💥 This achievement is a tremendous honor not only for Brayden, but for New Haven High School and our entire community. His leadership will showcase the strength, determination, and talent of New Haven students on a state and national stage.
In just our second year as a DECA chapter, this moment proves one thing:
🚀 New Haven doesn’t wait for opportunities—we create them.
👏 Join us in celebrating Brayden’s incredible accomplishment!
Drop a 🔥 in the comments to show your support!
#NewHavenRockets #DECA #MichiganDECA #StudentLeadership #CTEExcellence #FutureLeaders #RocketPride 🚀
New Haven High School is proud to celebrate an extraordinary achievement by Brayden Celeste, who has been elected as a Michigan DECA State Officer, representing over 10,000 members across the state of Michigan. 👏🔥
After advancing through a highly competitive and rigorous selection process—including a formal interview in Lansing, a full campaign, and election by voting delegates from across the state—Brayden earned his place among Michigan’s top student leaders.
🎤 “Mrs. M believed in me before anyone else did. This means everything, and I’m proud to represent New Haven on the biggest stage.”
As a State Officer, Brayden will:
✨ Lead statewide initiatives
✨ Represent Michigan at conferences across the country
✨ Mentor thousands of student leaders
✨ Serve as the voice of Michigan DECA
💥 This achievement is a tremendous honor not only for Brayden, but for New Haven High School and our entire community. His leadership will showcase the strength, determination, and talent of New Haven students on a state and national stage.
In just our second year as a DECA chapter, this moment proves one thing:
🚀 New Haven doesn’t wait for opportunities—we create them.
👏 Join us in celebrating Brayden’s incredible accomplishment!
Drop a 🔥 in the comments to show your support!
#NewHavenRockets #DECA #MichiganDECA #StudentLeadership #CTEExcellence #FutureLeaders #RocketPride 🚀




NHCS athletic schedule for the week of 3/15/26.

Thank you to everyone who came out and supported the Students vs. Staff Basketball Game! It was a great night filled with fun, friendly competition, and an amazing turnout from our community.
We appreciate everyone who participated in the raffles, bake sale, free throw contest, and concessions. Your support helps benefit Metastatica and the important work they do for those battling metastatic cancer.
A special shoutout to Endeavour Cheer for a great halftime performance and to all of our students and staff who made the game such a fun event.
We appreciate everyone who participated in the raffles, bake sale, free throw contest, and concessions. Your support helps benefit Metastatica and the important work they do for those battling metastatic cancer.
A special shoutout to Endeavour Cheer for a great halftime performance and to all of our students and staff who made the game such a fun event.









Shoutout to Tristen for knowing the most digits of pi in Mrs. Schmidt's challenge on Friday. Impressive memory and great job representing the spirit of math! Happy Pi Day!

Happy Pie Day (3.14)!
The Endeavour PTO knows how to celebrate!

Our own Brayden Celeste has been selected as a Michigan DECA State Officer, an incredible honor that puts him in a leadership role representing New Haven, our district, and Macomb County at conferences and events across the country this year.
To help support the travel that comes with this opportunity, we’re hosting a DECA fundraiser at QDOBA on Tuesday, March 24 from 4–8 PM (23 Mile Road in New Baltimore). If you stop in during that time and mention New Haven High School or DECA , 25% of your purchase will be donated to New Haven DECA.
We’re extremely proud of Brayden and excited to see him represent our community on a larger stage. If you’re able, consider grabbing dinner that night and helping support one of our Rockets and share it on social media with friends and family in the area.
To help support the travel that comes with this opportunity, we’re hosting a DECA fundraiser at QDOBA on Tuesday, March 24 from 4–8 PM (23 Mile Road in New Baltimore). If you stop in during that time and mention New Haven High School or DECA , 25% of your purchase will be donated to New Haven DECA.
We’re extremely proud of Brayden and excited to see him represent our community on a larger stage. If you’re able, consider grabbing dinner that night and helping support one of our Rockets and share it on social media with friends and family in the area.


The Shelby Township Police Department is offering a Women’s Self-Defense course. If you're interested, check out the flyer for details.
This week in Anatomy & Physiology at NHHS, students explored the special senses through a hands-on eye dissection! By examining the structures of the eye firsthand, they connected classroom concepts to real anatomy and gained a deeper understanding of how vision works. Experiential learning at its best!
Interested in supporting the New Haven Trap and Skeet Team? Check out the flyer for details on their upcoming Meat Bingo event!

Endeavour is celebrating Under the Sea Day as part of March is Reading Month!


The MRS conference opened with a delicious breakfast and fun activities. Students learned what it was like to have different disabilities. They had to complete tasks with oven mitts, follow directions with headphones on, and find their way with blindfolds on. We finished with a Q and A session that included a variety of professionals. Students earned gift cards for asking questions.





Students in AP Biology genetically modified the bacteria E. coli with a small segment of DNA called pVIB. The result is E. coli that glows blue. During this lab students practiced aseptic technique and small volume metrology, both are marketable skills used in the biotech workplace. This is the same process laboratories use today to modify E. coli to produce 40 tons of human insulin every year for treating type 1 diabetes.

Our high school students recently took a field trip to the Southeast Michigan Construction Academy to explore careers in the skilled trades. It was a great opportunity for our seniors to learn about high-demand careers and the programs that can help them get started right after graduation!








NHCS athletic schedule for the week of 3/8/26.

